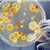

Christian Heesch
follows
4
collections
Christian Heesch
follows
4
collections
-
- Conscious Health
- 1 publication
-
- Health and Life Sciences
- 3 publications
-
- Public Health Alert
- 3 publications
-
- Survey of Health Center Oral Health Providers
- 1 publication








